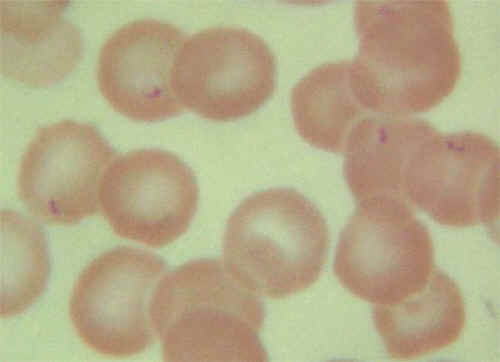

| Home | New Foto | Contatti | FAQ | Webmaster | Links | Ringraziamenti | Testi consigliati | Directory |
|
|
La Babesiosi
( immagine: http://w3vet.agri.kagoshima-u.ac.jp/ ) La specie più diffusa è la B.canis inoculata da Rhipicefalus sanguineus. Si possono anche frequentemente osservare ipereccitabilità associata alla babesiosi cerebrale. Altre manifestazioni attribuite allinfezione sono ascite, bronchite, porpora e dolori muscolari. La diagnosi è effettuata tramite striscio di sangue. Spesso linfezione è complicata dalla presenza di Ehrlichia canis anchessa trasmessa dalla stessa zecca. La terapia si base sulla somministrazione di Imidocarb in un'unica somministrazione al sospetto clinico; ripetere dopo 14gg se si sospetta una concomitante infezione da ehrlichia. Utile la somministrazione di una terapia di supporto. La profilassi si base sulla lotta al vettore (con prodotti antiparassitari) e su un vaccino Pirodog che però non da una copertura sicura al 100%.
( immagini: http://www.personalconsult.com/ )
|
||||
| Copyright © Difossombrone.it tutti i diritti sono riservati | |||||
|---|---|---|---|---|---|